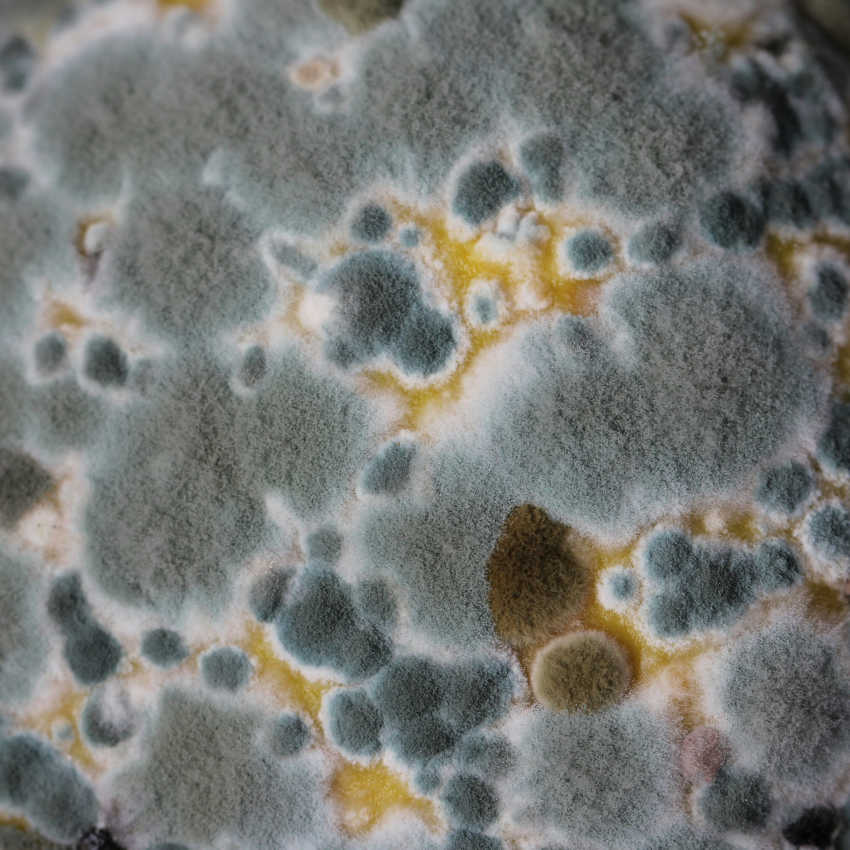

The Science: Our 7-Step Process for Optimal Health
Our commitment to your well-being is backed by rigorous research, ensuring every product is healthy, delicious, and nutritious.

Personal Commitment to Quality
1. James' Health Mission
With over 14 years in the coffee industry and a deep passion for biohacking, James frequently visits coffee farms to ensure they meet the highest health and quality standards.
His dedication to health optimisation and high-quality coffee is the foundation of our mission to enhance your well-being.
LAB CERTIFIED FOR PURITY
2. Toxin & Mould-Free Guarantee
We are committed to providing coffee that is 100% free from mould, mycotoxins and pesticides.
Our extensive research study and lab verified certificates underscores our commitment to your health, ensuring every cup you enjoy is pure and safe.

Grounded in Rigorous Research
3. Science-Backed Research
Our dedication to your well-being is grounded in rigorous scientific research, ensuring every product we offer is the healthiest, tastiest, and most nutritious.
We review the latest studies and collaborate with scientific experts to refine our products, focusing on maximising health benefits, enhancing antioxidant levels, and supporting overall wellness.
Through these efforts, we guarantee that every cup of Balance Coffee contributes positively to your health.

Expert Approved Wellness
4. Verified by Nutrionists
We consult experts like Clemmie Rose, who has worked with Google and Harrods, and has been featured in Vogue and GQ.
Her insights on nutrition and gut health enhance the quality and efficacy of our coffee and mushroom products.
This ensures our products taste great and deliver optimal health benefits, supporting your well-being.

Direct Relationships with Farmers
5. Meticulous Sourcing
By building direct relationships with farmers, we ensure a 100% chemical-free process, delivering high grade coffee with significant health advantages.
This hands-on approach allows us to secure coffee from the top 1% of farms worldwide, guaranteeing the finest quality for our customers.
Innovation and growth are core to Balance Coffee. We continuously innovate, including our mushroom products that offer transformative benefits.

Holistic Health Approach
6. Coffee & Mushroom Integration
Our journey expanded to include functional mushrooms, now a fundamental pillar of what we do.
This integration supports a holistic approach to health, combining the benefits of high-quality coffee with powerful adaptogenic mushrooms.
Our unique formulation ensures that the mushroom elixirs pair seamlessly with your coffee, maintaining perfect texture and taste without any mushroom flavour.

Optimal Flavour and Nutrition
7. Roasting: Unlocking the Best in Every Bean
Understanding the chemical journey during roasting is vital for extracting maximum goodness from the beans.
We focus on a medium-light roast profile to retain a higher level of antioxidants, ensuring you get the most health benefits.
Whether you prefer light, medium, or medium-dark roasts, we cater to your taste, delivering exceptional flavour in every cup.